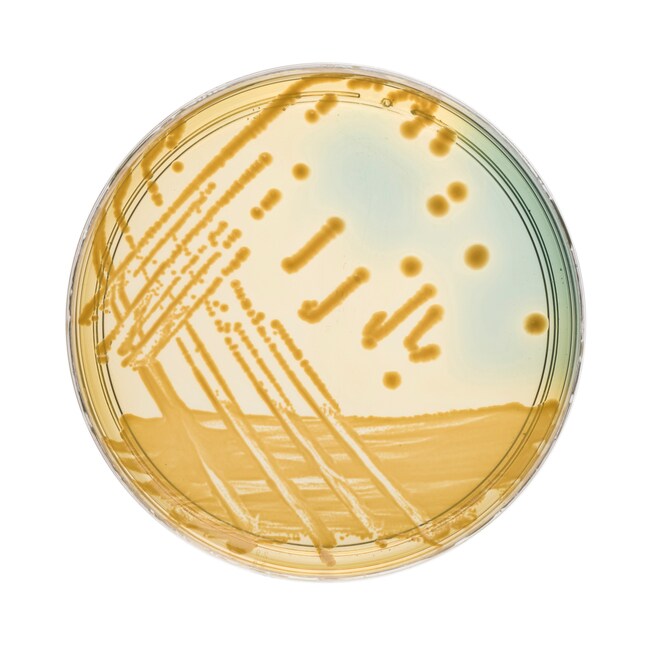
TCBS Cholera Medium

Search
Search
| 货号 | 描述 |
|---|---|
| PO0194A | TCBS Cholera Medium |
Selectively isolate pathogenic Vibrio species with Thermo Scientific™ Oxoid™ TCBS (Thiosulfate Citrate Bile Salts Sucrose) Cholera Medium. The medium has shown to be the most satisfactory and reproducible formula regardless of the complex composition1. Unlike Lauryl Sulphate Tellurite Agar it does not require further additives or aseptic additions of blood. It also possesses superior growth characteristics for Vibrio species, compared with tellurite media. While inhibiting non-vibrios, it promotes rapid growth of pathogenic vibrios after overnight incubation at 35°C.
Use TCBS Cholera Medium for selective isolation of pathogenic vibrios.
The TCBS medium conforms to the formulation of Kobayashi et al., except that it contains specially processed ox bile, free from the defects noted by Nakanishi and Kobayashi2.
Not all products are available for sale in all territories. Please inquire.
Remel™ and Oxoid™ products are now part of the Thermo Scientific brand.
1. West P. A., Russek E., Brayton P. R. and Colwell P. R. (1982) J. Clin. Microbiol. 16. 1110-1116.
2. Kobayashi T., Enomoto S., Sakazaki R. and Kuwahara S. (1963) Jap. J. Bacteriol. 18. 10-11, 387-311